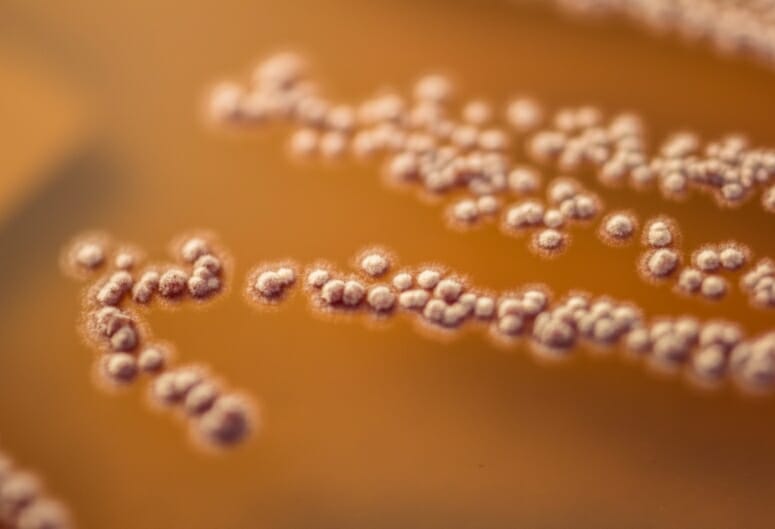

Bacteriology fields Cool Science Image Contest winner
Caitlin Carlson, a research specialist in Bacteriology, was one of 10 UW–Madison faculty, staff and students to have been named winners of the 2018 Cool Science Image Contest. A panel of eight experienced artists and scientists judged the scientific content and aesthetic and creative qualities of 171 images and videos, a record number of entries for the eighth annual competition.
Carlson’s winning photo shows bacteria colonies cultured from a Costa Rican parasitoid wasp. The bacteria were prospects in her search for new antimicrobial compounds.
Ahna Skop, professor of genetics, served as a judge in the contest.
“Beauty drives curiosity for me, as a scientist. It’s the same for people who are curious, but not scientists,” Skop says. “When people see a good image you’ve made, they say, ‘That looks amazing. Tell me what it is.'”
The 2018 winners were made with intricate, high-tech tools over the course of days of capturing and processing; with smartphone cameras pulled from pockets to catch a moment of serendipity; and with all manner of methods in-between.
Some of the other subjects are plants, animals and minerals, pictured from a distance — a safe distance, in the case of one carnivorous king of the jungle — down to the graceful nanoscale arrangement of metallic molecules.
“It’s all data, on some level, but it’s often beautiful,” says Skop, who grew up in a house full of artists, and creates her own art in and out of the lab. “As a microscopist, we work to visualize things you can’t see with the human eye. And for many of us, our technical skill and how we see this mysterious and beautiful world influences how we frame and capture the image. And more often than not we discover works of art.”
To see the other winning entrants, visit the UW–Madison news website.

